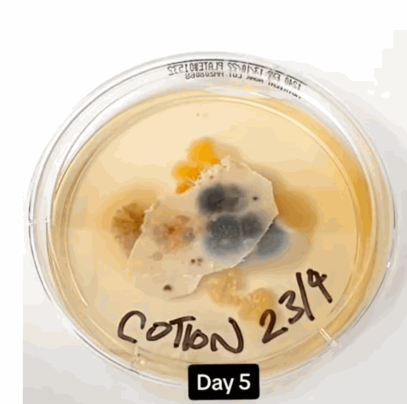
枕头套的情况 枕头套的情况

枕头套短时间内可滋生惊人细菌数量,并引发脑膜炎?惊人变化全记录!美国有研究发现,枕头套7日不洗,积聚的细菌比厕所板多1.7万倍,严重可致休克及脑膜炎!专家建议更换枕头套的最佳时间,并教5招预防床具细菌。
枕头套7日不洗 细菌比厕板多1.7万倍
根据英国邮报报道,该研究采集未清洗的枕头套样本,培养7天后发现,枕头套死皮细胞、唾液污染,以及许多肉眼所看不见的真菌和细菌,细菌含量将比马桶盖多出17000倍。
美国康奈尔大学威尔医学院皮肤科博士Hadley King解释指,床单每天都会被5000万个死皮屑、汗液、化妆品、乳液、头发和宠物皮屑等污染。此外,死皮细胞和汗液是尘螨的食物,它们会吸引尘螨到床上繁殖,导致细菌和病毒的滋生。
枕头套7日不洗惊人变化全记录
床单公司AmeriSleep曾进行维期4星期的实验,每星期采集3名受试者未洗的枕头套,结果发现枕头套上每平方英寸的细菌数量竟高达300万到500万个,当中包括杆菌和革兰氏阳性球菌。
▲5天枕头套的情况。
引发10大健康问题 不换枕头套恐致脑膜炎
Dr. Hadley King指枕头套含有的细菌和病毒,均可能导致皮肤过敏、感染或发炎。这些细菌包括:金黄色葡萄球菌(Staphylococcus)、杆菌(Bacilli )和革兰氏阳性球菌( Gram-positive cocci),可能会引致以下10种健康问题:
枕头套细菌1:金黄色葡萄球菌
皮肤感染(疖子(脓疮))
蜂窝性组织炎
枕头套细菌2:杆菌
眼部感染
心内膜炎
菌血症
败血症
肺炎
脑膜炎
肌肉骨骼感染
枕头套细菌3:革兰氏阳性球菌
中毒性休克综合症
除了引起健康问题的细菌之外,AmeriSleep的研究更发现,枕头套上亦会有床虱,导致起床时会全身发痒,脸上、颈子和肩膀也会发现床虱的咬痕。
睡前1习惯是关键5招减少床具细菌
报道引述研究建议,民众应于24天内更换并清洗枕头套。皮肤科医生哈德利(Dr. Hadley King)则建议每周至少清洗2次,定期清洗枕头套和床单可以有效避免细菌和病毒的繁殖,减少皮肤感染和发炎等健康风险。
台湾毒理学专家招名威教授亦曾在Facebook专页发文指,有研究指发现枕头平均可滋生多达16种霉菌和尘螨,并指出以下5招减低床具细菌:
床具减菌方法1:吹干头发
头发一定要吹干才可睡在枕头上,否则湿气直接留在枕头上,造成又湿又暖的环境容易吸引微生物。
床具减菌方法2:清洁枕头
有些可水洗的枕心材质,建议定期清洗。
如果是无法水洗的乳胶记忆枕,建议套上枕头套,并每个礼拜更换一次,避免头皮直接接触到枕心,减少人体头皮屑、脸的皮屑,或是口水、眼泪附着在枕头上。
床具减菌方法3:枕心底枕头套污迹
若枕头已经出现清不掉的污迹、黄斑,代表这颗枕头已经太脏,容易令人长痘,建议更换新的枕头。
床具减菌方法4:忌起床折被
人睡觉时会流汗,这些水气若没有散失的话很容易让床铺的湿度增加。所以起床时把棉被铺好,反而会将湿气覆盖在里面,再加上不常清理被单,床上的尘满存活密度肯定会很高。建议起床后先反转棉被,让湿气自然蒸发。
床具减菌方法5:床具晒太阳
除了清洗之外,棉被、床单、枕头这些也都应该每周晒太阳一次,不然就用烘被机来烘一烘,少说半个钟头以上,也可以达到高温杀菌的效果喔。
更多生活小知识,尽在星岛环球网:
以上内容归星岛新闻集团所有,未经许可不得擅自转载引用。